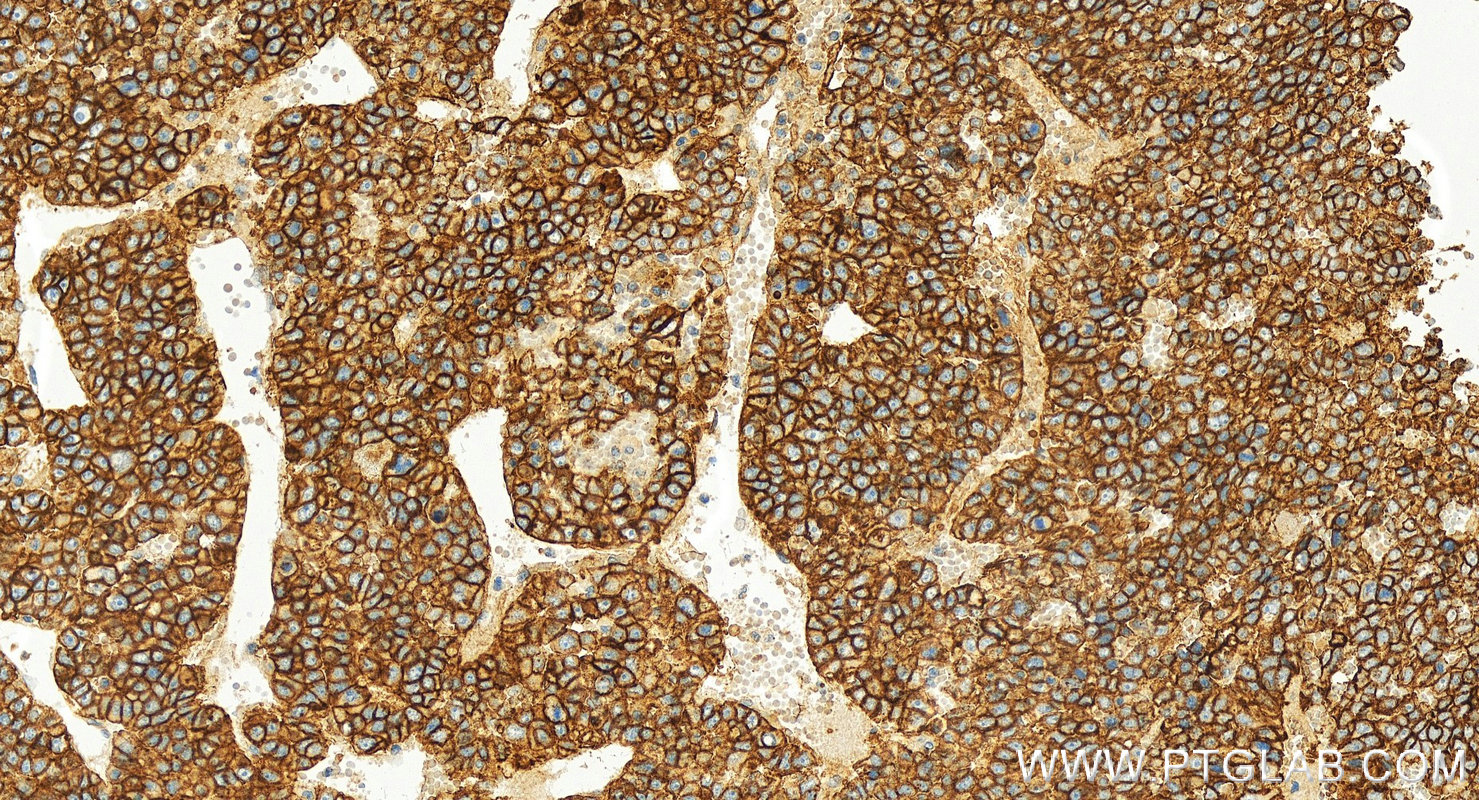
IHC staining of human hepatocellular ca using 55187-1-AP

验证数据展示
经过测试的应用
| Positive WB detected in | 37°C incubated mouse brain tissue, HEK-293 cells, mouse brain tissue, mouse heart tissue, Neuro-2a cells, MCF-7 cells |
| Positive IHC detected in | human ovary cancer tissue, human colon tissue, human hepatocellular ca, human liver cancer tissue, mouse kidney tissue Note: suggested antigen retrieval with TE buffer pH 9.0; (*) Alternatively, antigen retrieval may be performed with citrate buffer pH 6.0 |
| Positive IF/ICC detected in | HEK-293 cells, Caco-2 cells |
| Positive FC (Intra) detected in | HEK-293 cells |
For optimal WB detection with 55187-1-AP, we do not recommend boiling the sample after lysis.
推荐稀释比
| 应用 | 推荐稀释比 |
|---|---|
| Western Blot (WB) | WB : 1:5000-1:50000 |
| Immunohistochemistry (IHC) | IHC : 1:500-1:2000 |
| Immunofluorescence (IF)/ICC | IF/ICC : 1:500-1:2000 |
| Flow Cytometry (FC) (INTRA) | FC (INTRA) : 0.40 ug per 10^6 cells in a 100 µl suspension |
| It is recommended that this reagent should be titrated in each testing system to obtain optimal results. | |
| Sample-dependent, Check data in validation data gallery. | |
产品信息
55187-1-AP targets ATP1A1-Specific in WB, IHC, IF/ICC, FC (Intra), ELISA applications and shows reactivity with human, mouse samples.
| 经测试应用 | WB, IHC, IF/ICC, FC (Intra), ELISA Application Description |
| 文献引用应用 | WB, IHC, IF |
| 经测试反应性 | human, mouse |
| 文献引用反应性 | human, mouse, rat |
| 免疫原 |
Peptide 种属同源性预测 |
| 宿主/亚型 | Rabbit / IgG |
| 抗体类别 | Polyclonal |
| 产品类型 | Antibody |
| 全称 | ATPase, Na+/K+ transporting, alpha 1 polypeptide |
| 别名 | ATP1A1, ATP1A 1, Atpa 1, EC:7.2.2.13, Na(+)/K(+) ATPase 1 |
| 计算分子量 | 113 kDa |
| 观测分子量 | 100-110 kDa |
| GenBank蛋白编号 | NM_000701 |
| 基因名称 | ATP1A1 |
| Gene ID (NCBI) | 476 |
| ENSEMBL Gene ID | ENSG00000163399 |
| RRID | AB_10859261 |
| 偶联类型 | Unconjugated |
| 形式 | Liquid |
| 纯化方式 | Antigen affinity purification |
| UNIPROT ID | P05023 |
| 储存缓冲液 | PBS with 0.02% sodium azide and 50% glycerol, pH 7.3. |
| 储存条件 | Store at -20°C. Stable for one year after shipment. Aliquoting is unnecessary for -20oC storage. |
背景介绍
ATP1A1 is the catalytic component of Na+/K+-ATPase which is a membrane bound enzyme primarily involved in generation of Na+ and K+ gradients across plasma membranes and in determination of cytoplasmic Na+ levels. ATP1A1 is a ubiquitously expressed membrane protein and often used as the marker or internal control for plasma membrane protein. This antibody is specific to ATP1A1.
实验方案
| Product Specific Protocols | |
|---|---|
| FC protocol for ATP1A1-Specific antibody 55187-1-AP | Download protocol |
| IF protocol for ATP1A1-Specific antibody 55187-1-AP | Download protocol |
| IHC protocol for ATP1A1-Specific antibody 55187-1-AP | Download protocol |
| WB protocol for ATP1A1-Specific antibody 55187-1-AP | Download protocol |
| Standard Protocols | |
|---|---|
| Click here to view our Standard Protocols |
发表文章
| Species | Application | Title |
|---|---|---|
Autophagy Hepatocyte CD36 modulates UBQLN1-mediated proteasomal degradation of autophagic SNARE proteins contributing to septic liver injury | ||
Nat Commun CLICs-dependent chloride efflux is an essential and proximal upstream event for NLRP3 inflammasome activation. | ||
Adv Healthc Mater Effect of Nanoparticle Rigidity on the Interaction of Stromal Membrane Particles with Leukemia Cells | ||
Hypertension Renal Natriuretic Peptide Receptor-C Deficiency Attenuates NaCl Cotransporter Activity in Angiotensin II-Induced Hypertension. | ||
Cell Chem Biol The HEAT repeat protein MROH7 regulates the inflammatory macrophage response via LBP acetylation | ||